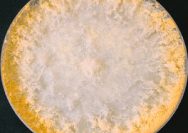

Kamis, 16 April 2026
Indoaktual, Lombok - Kalau ada satu penyesalan yang paling aku ingat dari perjalanan pertamaku ke Lombok, bukan soal tempat yang…
Kamis, 16 April 2026
Indoaktual, Jakarta - Pegadaian Kantor Wilayah IX menegaskan komitmennya dalam menjaga kepercayaan masyarakat melalui pelayanan yang profesional, transparan, dan berlandaskan prinsip…
Kamis, 16 April 2026
Musyawarah Nasional (Munas) XVIII Himpunan Pengusaha Muda Indonesia 2026 akan digelar pada juni mendatang. Munas ini merupakan agenda rutin pergantian…
Kamis, 16 April 2026
Industrial estate planning is often the "make or break" moment for businesses ready to scale from a small operation to…
Kamis, 16 April 2026
Neurospora Sitophila adalah salah satu jenis jamur mikroskopis yang menarik dan sering digunakan dalam penelitian ilmiah. Dikenal dengan nama ilmiah…
Daerah
indo update
Indo Video

▶
3:39:34

▶
0:07:46

▶
1:33:56

▶
1:03:53
Latest Inline Widget
8 jam yang lalu
5 jam yang lalu
indo Topic
4 Artikel
#Jasa
4 Artikel
#Buku
1 Artikel
#Bulu Tangkis
1 Artikel
#Makan Gratis
1 Artikel
#Gus Yasin
2 Artikel
#Kebiasaan
15 Artikel
#website
27 Artikel
#Telkom
Latest Inline Widget
15 jam yang lalu
19 jam yang lalu
Indo Kuliner
Latest Outline Widget
24 jam yang lalu
1 hari yang lalu